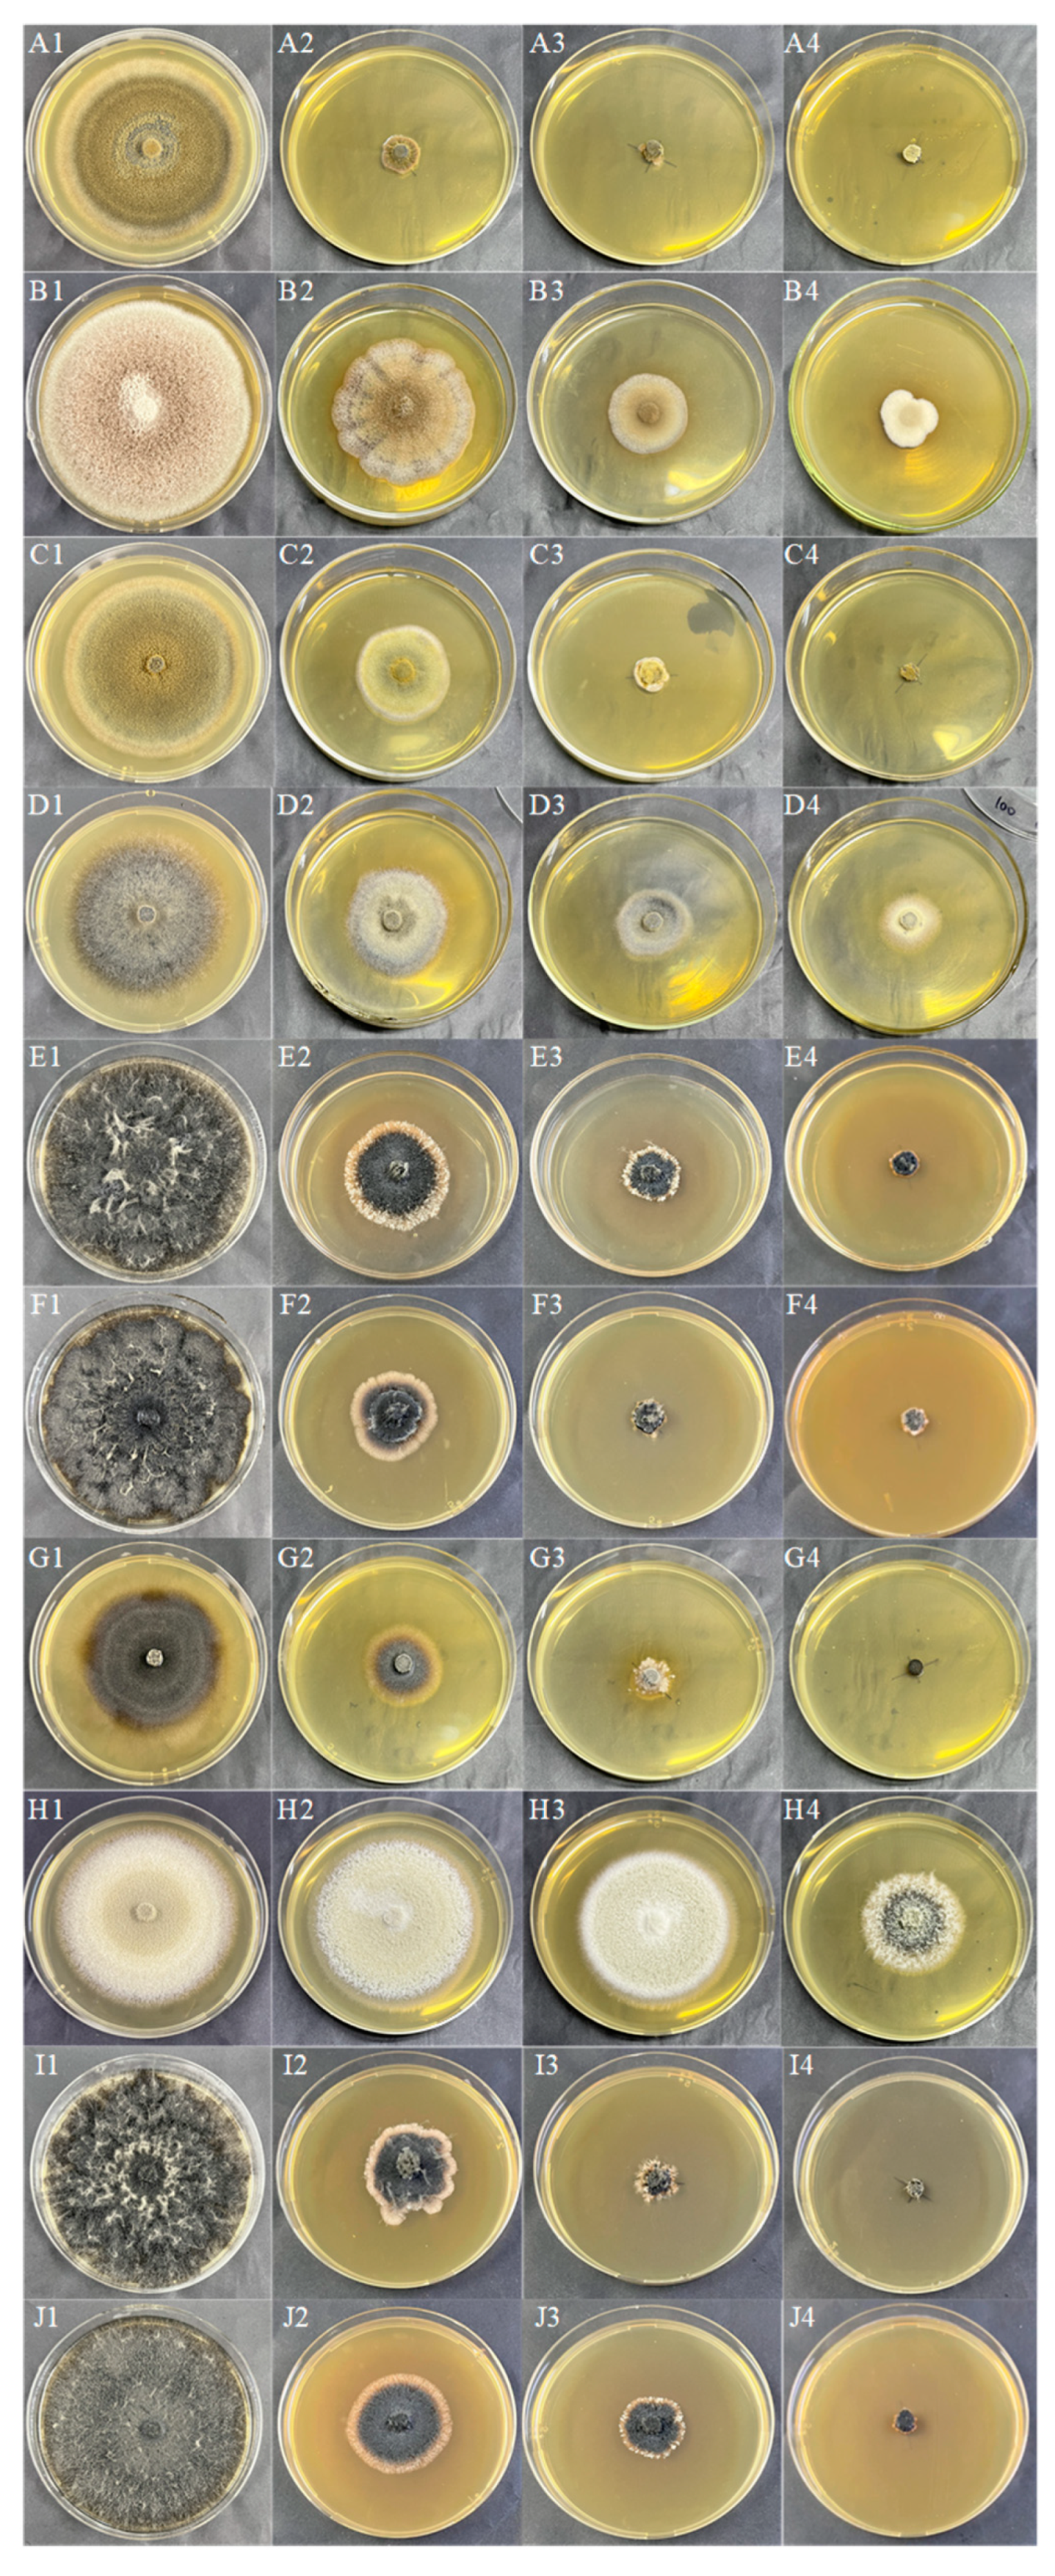
Jof 10 00491 g004

Study on the Biological Characteristics of Dark Septate Endophytes under Drought and Cadmium Stress and Their Effects on Regulating the Stress Resistance of Astragalus membranaceus
Abstract
1. Introduction
2. Materials and Methods
2.1. Fungal Materials of DSE
2.2. Growth Conditions
2.3. Drought Tolerance of DSE Strains
2.4. Cd Tolerance of DSE Strains
2.5. Drought and Cd Tolerance of DSE Strains
2.5.1. Solid Culture of DSE
2.5.2. Liquid Culture of DSEs
2.6. DSE Growth and Cd Content
2.7. Determination of DSE Antioxidant Enzyme Activity
2.8. Determination of DSE Resistance Parameters
2.9. Statistical Analysis
3. Results
3.1. Effect of Drought Stress on Morphology and Growth of DSE Colonies
3.2. Effect of Cd Stress on Morphology and Growth of DSE Colonies
3.3. Effects of Combined Stress of Drought and Cd on Morphology and Physiological Indices of DSE Colonies
3.3.1. Morphological Parameters and Biomass of DSE Colonies
3.3.2. Melanin and Cd Content of DSE Strains
3.3.3. Soluble Substance Content of DSE Strains
3.3.4. GSH and MDA Content of DSE Strains
3.3.5. Antioxidant Enzyme Activity of DSE Strains
3.4. Relationship between DSE Growth and Physiological Indicators
3.5. Variation Partitioning Analyses
3.6. Correlation Analyses
3.7. Growth Parameter
4. Discussion
4.1. Effects of Drought Stress on the Performance of DSE
4.2. Effects of Cd Stress on the Performance of DSE
4.3. Effects of Combined Drought and Cd Stress on the Performance of DSE
4.4. Effects of DSE on Growth Performance of Astragalus membranaceus under Drought and Cd Stress
5. Conclusions
6. Patents
Author Contributions
Funding
Institutional Review Board Statement
Informed Consent Statement
Data Availability Statement
Conflicts of Interest
References
- Sintaha, M.; Man, C.K.; Yung, W.S.; Duan, S.; Li, M.W.; Lam, H.M. Drought stress priming improved the drought tolerance of soybean. Plants 2022, 11, 2954. [Google Scholar] [CrossRef] [PubMed]
- Caser, M.; D’Angiolillo, F.; Chitarra, W.; Lovisolo, C.; Ruffoni, B.; Pistelli, L.; Pistelli, L.; Scariot, V. Ecophysiological and phytochemical responses of Salvia sinaloensis Fern. to drought stress. Plant Growth Regul. 2018, 84, 383–394. [Google Scholar] [CrossRef]
- Gao, Y.; Li, H.P.; Song, Y.; Zhang, F.L.; Yang, Z.G.; Yang, Y.; Grohmann, T. Response of glutathione pools to cadmium stress and the strategy to translocate cadmium from roots to leaves (Daucus carota L.). Sci. Total Environ. 2022, 823, 153575. [Google Scholar] [CrossRef] [PubMed]
- Liu, X.R.; Chen, L.H.; Zhang, J.; He, S.H. Effects of drought and cadmium pollution on the physiology and cadmium enrichment of Pennisetum sinese. Acta Bot. Boreal.—Occid. Sin. 2019, 39, 277–284. [Google Scholar]
- Cheng, Y.X.; Qiu, L.Z.; Shen, P.K.; Wang, Y.Q.; Li, J.L.; Dai, Z.Y.; Qi, M.F.; Zhou, Y.; Zou, Z.K. Transcriptome studies on cadmium tolerance and biochar mitigating cadmium stress in muskmelon. Plant Physiol. Biochem. 2023, 197, 107661. [Google Scholar] [CrossRef] [PubMed]
- Ji, B.Y.; Xuan, L.S.; Zhang, Y.X.; Zhang, G.Q.; Meng, J.; Mu, W.R.; Liu, J.J.; Paek, K.Y.; Park, S.Y.; Wang, J.; et al. Advances in biotechnological production and metabolic regulation of Astragalus membranaceus. Plants 2023, 12, 1858. [Google Scholar] [CrossRef] [PubMed]
- Zhao, R. Systematic Evaluation of Heavy Metal Pollution of Eight Chinese Herbal Medicines in China; Beijing University of Chinese Medicine: Beijing, China, 2016. [Google Scholar]
- Islam, M.; Sandhi, A. Heavy metal and drought stress in plants: The role of microbes-A review. Gesunde Pflanz. 2023, 75, 695–708. [Google Scholar] [CrossRef]
- Xie, L.L.; He, X.L.; Wang, K.; Hou, L.F.; Sun, Q. Spatial dynamics of dark septate endophytes in the roots and rhizospheres of Hedysarum scoparium in northwest China and the influence of edaphic variables. Fungal Ecol. 2017, 26, 135–143. [Google Scholar] [CrossRef]
- Akhtar, N.; Wani, A.K.; Dhanjal, D.S.; Mukherjee, S. Insights into the beneficial roles of dark septate endophytes in plants under challenging environment: Resilience to biotic and abiotic stresses. World J. Microbiol. Biotechnol. 2022, 38, 79. [Google Scholar] [CrossRef]
- Newsham, K.K. A meta-analysis of plant responses to dark septate root endophytes. New Phytol. 2011, 190, 783–793. [Google Scholar] [CrossRef]
- Li, X.; He, X.L.; Hou, L.F.; Ren, Y.; Wang, S.J.; Su, F. Dark septate endophytes isolated from a xerophyte plant promote the growth of Ammopiptanthus mongolicus under drought condition. Sci. Rep. 2018, 8, 7896. [Google Scholar] [CrossRef] [PubMed]
- Wang, J.L.; Li, T.; Liu, G.Y.; Smith, J.M.; Zhao, Z.W. Unraveling the role of dark septate endophyte (DSE) colonizing maize (Zea mays) under cadmium stress: Physiological, cytological and genic aspects. Sci. Rep. 2016, 6, 22028. [Google Scholar] [CrossRef]
- Xu, M.H.; Li, X.; Ye, Q.N.; Gong, F.; He, X.L. Occurrence of dark septate endophytes in Phragmites australis in Baiyang Lake and their resistance to Cd stress. Pedosphere 2023, 34, 484–496. [Google Scholar] [CrossRef]
- Li, M.; Hou, L.F.; Liu, J.Q.; Yang, J.Y.; Zuo, Y.L.; Zhao, L.L.; He, X.L. Growth-promoting effects of dark septate endophytes on the non-mycorrhizal plant Isatis indigotica under different water conditions. Symbiosis 2021, 85, 291–303. [Google Scholar] [CrossRef]
- He, C.; Wang, W.; Hou, J. Plant Growth and soil microbial impacts of enhancing licorice with inoculating dark septate endophytes under drought stress. Front. Microbiol. 2019, 10, 2277. [Google Scholar] [CrossRef]
- Li, X.; Liu, Y.X.; Ye, Q.N.; Xu, M.H.; He, X.L. Application of desert DSEs to nonhost plants: Potential to promote growth and alleviate drought stress of wheat seedlings. Agriculture 2022, 12, 1539. [Google Scholar] [CrossRef]
- Xiao, Y.; Dai, M.X.; Zhang, G.Q.; Yang, Z.X.; He, Y.M.; Zhan, F.D. Effects of the dark septate endophyte (DSE) Exophiala pisciphila on the growth of root cell wall polysaccharides and the cadmium content of Zea mays L. under cadmium stress. J. Fungi 2021, 7, 1035. [Google Scholar] [CrossRef]
- Chen, S.; Zhang, G.; Liang, X.; Wang, L.; Li, Z.; He, Y.; Li, B.; Zhan, F. A Dark septate endophyte improves cadmium tolerance of maize by modifying root morphology and promoting cadmium binding to the cell wall and phosphate. J. Fungi 2023, 9, 531. [Google Scholar] [CrossRef]
- Su, Z.Z.; Dai, M.D.; Zhu, J.N.; Liu, X.H.; Li, L.; Zhu, X.M.; Wang, J.Y.; Yuan, Z.L.; Lin, F.C. Dark septate endophyte Falciphora oryzae-assisted alleviation of cadmium in rice. J. Hazard. Mater. 2021, 419, 126435. [Google Scholar] [CrossRef]
- Bi, Y.L.; Xie, L.L. Functions of arbuscular mycorrhizal fungi and dark septate endophytes in ecological restoration. Acta Microbiol. Sin. 2021, 61, 58–67. [Google Scholar]
- Yang, X.R. Species Diversity and Drought Tolerance of Dark Septate Endophytes from Different Germplasm of Glycyrrhiza uralensis Fisch. Master’s Thesis, Hebei University, Baoding, China, 2023. [Google Scholar]
- Yao, J.J. Effects of DSE Fungi Combined with Organic Residues on Growth and Nutrient Absorption of Isatis indigotica under Drought Stress. Master’s Thesis, Hebei University, Baoding, China, 2022. [Google Scholar]
- Ren, Y.F. Study on Growth Promoting and Drought Resistance Potential of Astragalus membranaceus by Double Inoculation of DSE Fungi and Trichoderma spp. Master’s Thesis, Hebei University, Baoding, China, 2022. [Google Scholar]
- Shi, J.X. Spatiotemporal Distribution and Drought Promotion of Dark Septate Endophytes Fungi in Lycium ruthenicum in Northwest China. Master’s Thesis, Hebei University, Baoding, China, 2021. [Google Scholar]
- Wei, M. Resources Distribution and Salt Tolerance of Dark Septate Endophytes in Lycium ruthenicum in Northwest Desert Region. Master’s Thesis, Hebei University, Baoding, China, 2022. [Google Scholar]
- Han, L. Species Diversity and Cd Tolerance of Dark Septate Endophytes in Medicinal Plant in Anguo. Hebei Province. Doctoral Thesis, Hebei University, Baoding, China, 2022. [Google Scholar]
- Li, M.; He, C.; Wei, M.; Long, J.M.; Wang, J.R.; Yang, X.R.; Wang, K.H.; He, X.L. Temporal and spatial dynamics and functional metabolism of dark septate endophytes of Gymnocarpos przewalskii Maxim. in Northwest Desert, China. Appl. Soil. Ecol. 2024, 194, 105194. [Google Scholar] [CrossRef]
- Ban, Y.H.; Xu, Z.Y.; Yang, Y.R.; Zhang, H.H.; Chen, H.; Tang, M. Effect of dark septate endophytic fungus Gaeumannomyces cylindrosporus on plant growth, photosynthesis and Pb tolerance of maize (Zea mays L.). Pedosphere 2017, 27, 283–292. [Google Scholar] [CrossRef]
- Bai, J.H.; Jia, X.M.; Wu, Y.Q.; Wang, Y.K.; Song, W.Y.; Liu, Y.N. Ability of DSE against abiotic stresses and improving drought resistance of Solanum tuberosu. Crops 2023, 39, 150–159. [Google Scholar]
- Medina-Armijo, C.; Isola, D.; Illa, J.; Puerta, A.; Viñas, M.; Prenafeta-Boldú, F.X. The metallotolerance and biosorption of As (V) and Cr (VI) by black fungi. J. Fungi 2024, 10, 47. [Google Scholar] [CrossRef] [PubMed]
- Tremarin, A.; Longhi, D.A.; Salomão, B.; Aragão, G.M.F. Modeling the growth of Byssochlamys fulva and Neosartorya fischeri on solidified apple juice by measuring colony diameter and ergosterol content. Int. J. Food Microbiol. 2015, 193, 23–28. [Google Scholar] [CrossRef] [PubMed]
- Melati, I.; Rahayu, G.; Surono; Effendi, H.; Henny, C.; Susanti, E. Chromium (VI) bioremediation potential of dark septate endophytic (DSE) fungi. IOP Conf. Ser. Earth Environ. Sci. 2023, 1201, 012077. [Google Scholar] [CrossRef]
- Ginnopol, C.N.; Ries, S.K. Superoxide dismutase: II. purification and quantitative relationship with water-soluble protein in seedling. Plant Physiol. 1997, 59, 315–318. [Google Scholar]
- Gao, J.F. Experimental Techniques in Plant Physiology; World Book Publishing House: Xi’an, China, 2000; pp. 137–202. [Google Scholar]
- Cai, Q.S. Experiments in Plant Physiology; China Agricultural University Press: Beijing, China, 2013. [Google Scholar]
- Gaber, D.A.; Berthelot, C.; Camehl, I.; Kovács, G.M.; Blaudez, D.; Franken, P. Salt stress tolerance of dark septate endophytes is independent of melanin accumulation. Front. Microbiol. 2020, 11, 562931. [Google Scholar] [CrossRef]
- Ellis, D.H.; Griffiths, D.A. The location and analysis of melanins in the cell walls of some soil fungi. Can. J. Microbiol. 1974, 20, 1379–1386. [Google Scholar] [CrossRef]
- Zhang, C.; Liu, F.; Kong, W.W.; He, Y. Application of visible and near-infrared hyperspectral imaging to determine soluble protein content in oilseed rape leaves. Sensors 2015, 15, 16576–16588. [Google Scholar] [CrossRef]
- Zhang, Z.L.; Qu, W.J. Laboratory Instruction of Plant Physiology; Higher Education Press: Beijing, China, 2003. [Google Scholar]
- Li, Z.L.; Min, D.D.; Fu, X.D.; Zhao, X.M.; Wang, J.H.; Zhang, X.H.; Li, F.J.; Li, X.A. The roles of SlMYC2 in regulating ascorbate-glutathione cycle mediated by methyl jasmonate in postharvest tomato fruits under cold stress. Sci. Hortic. 2021, 288, 110406. [Google Scholar] [CrossRef]
- Jiao, W.X.; Liu, X.; Chen, Q.M.; Du, Y.M.; Li, Y.Y.; Yue, F.L.; Dong, X.Q.; Fu, M.R. Epsilon-poly-L-lysine (ε-PL) exhibits antifungal activity in vivo and in vitro against Botrytis cinerea and mechanism involved. Postharvest Biol. Technol. 2020, 168, 111270. [Google Scholar] [CrossRef]
- Lu, Z.K.; Li, M.; Ding, G.J. Growth characteristics of three ectomycorrhizal fungi under PEG-6000 stress. J. Northwest Forest. Univ. 2020, 35, 151–158. [Google Scholar]
- Yu, J.; He, X.L.; Zhao, L.L.; Su, F. Colonization and community composition of dark endophytic fungi in Fengfeng mining area of Hebei. J. Fungal Res. 2018, 16, 228–238. [Google Scholar]
- Yue, H.; Sun, X.M.; Wang, T.T.; Zhang, A.L.; Han, D.J.; Wei, G.H.; Song, W.N.; Shu, D.T. Host genotype-specific rhizosphere fungus enhances drought resistance in wheat. Microbiome 2024, 12, 44. [Google Scholar]
- Mirshad, P.P.; Puthur, J.T. Arbuscular mycorrhizal association enhances drought tolerance potential of promising bioenergy grass (Saccharum arundinaceum Retz.). Environ. Monit. Assess. 2016, 188, 425. [Google Scholar] [CrossRef]
- Begum, N.; Akhtar, K.; Ahanger, M.A.; Iqbal, M.; Wang, P.; Mustafa, N.S.; Zhang, L. Arbuscular mycorrhizal fungi improve growth, essential oil, secondary metabolism, and yield of tobacco (Nicotiana tabacum L.) under drought stress conditions. Environ. Sci. Pollut. Res. 2021, 28, 45276–45295. [Google Scholar] [CrossRef] [PubMed]
- Silambarasan, S.; Logeswari, P.; Vangnai, A.S.; Kamaraj, B.; Cornejo, P. Plant growth-promoting actinobacterial inoculant assisted phytoremediation increases cadmium uptake in Sorghum bicolor under drought and heat stresses. Environ. Pollut. 2022, 307, 119489. [Google Scholar] [CrossRef]
- Zhu, L.L.; Li, T.; Wang, C.J.; Zhang, X.R.; Xu, L.J.; Xu, R.B.; Zhao, Z.W. The effects of dark septate endophyte (DSE) inoculation on tomato seedlings under Zn and Cd stress. Environ. Sci. Pollut. Res. 2018, 25, 35232–35241. [Google Scholar] [CrossRef]
- Shadmani, L.; Jamali, S.; Fatemi, A. Isolation, identification, and characterization of cadmium-tolerant endophytic fungi isolated from barley (Hordeum vulgare L.) roots and their role in enhancing phytoremediation. Braz. J. Microbiol. 2021, 52, 1097–1106. [Google Scholar] [CrossRef]
- Gonçalves, M.F.M.; Aleixo, A.; Vicente, T.F.L.; Esteves, A.C.; Alves, A. Three new species of Neocamarosporium isolated from saline environments: N. aestuarinum sp. nov., N. endophyticum sp. nov. and N. halimiones sp. nov. Mycosphere 2019, 10, 608–621. [Google Scholar]
- Hou, L.F.; Yu, J.; Zhao, L.L.; He, X.L. Dark septate endophytes improve the growth and the tolerance of Medicago sativa and Ammopiptanthus mongolicus under cadmium stress. Front. Microbiol. 2020, 10, 3061. [Google Scholar] [CrossRef] [PubMed]
- Lin, Y.B.; Wang, X.Y.; Wang, B.P.; Mohamad, O.; Wei, G.H. Bioaccumulation characterization of zinc and cadmium by Streptomyces zinciresistens, a novel actinomycete. Ecotoxicol. Environ. Saf. 2012, 77, 7–17. [Google Scholar] [CrossRef] [PubMed]
- Xue, S.P.; Wang, X.H. Inoculation of soil with cadmium-resistant Actinomycetes flora reduces cadmium accumulation in rice (Oryza Sativa L.). Int. J. Environ. Pollut. Remed. 2021, 9, 1–11. [Google Scholar]
- Li, X.; He, C.; He, X.L.; Su, F.; Hou, L.F.; Ren, Y.; Hou, Y.T. Dark septate endophytes improve the growth of host and non-host plants under drought stress through altered root development. Plant Soil 2019, 439, 259–272. [Google Scholar] [CrossRef]
- Bell, A.A.; Wheeler, M.H. Biosynthesis and functions of fungal melanins. Annu. Rev. Phytopathol. 1986, 24, 411–451. [Google Scholar] [CrossRef]
- Fernandez, C.W.; Koide, R.T. The function of melanin in the ectomycorrhizal fungus Cenococcum geophilum under water stress. Fungal Ecol. 2013, 6, 479–486. [Google Scholar] [CrossRef]
- Eisenman, H.C.; Greer, E.M.; McGrail, C.W. The role of melanins in melanotic fungi for pathogenesis and environmental survival. Appl. Microbiol. Biotechnol. 2020, 104, 4247–4257. [Google Scholar] [CrossRef]
- Berthelot, C.; Zegeye, A.; Gaber, D.A.; Chalot, M.; Franken, P.; Kovács, G.M.; Leyval, C.; Blaudez, D. Unravelling the role of melanin in Cd and Zn tolerance and accumulation of three dark septate endophytic species. Microorganisms 2020, 8, 537. [Google Scholar] [CrossRef]
- Zechmann, B. Compartment-specific importance of glutathione during abiotic and biotic stress. Front. Plant Sci. 2014, 5, 566. [Google Scholar] [CrossRef]
- Zhan, F.D.; Li, B.; Jiang, M.; Qin, L.; Wang, J.X.; He, Y.M.; Li, Y. Effects of a root-colonized dark septate endophyte on the glutathione metabolism in maize plants under cadmium stress. J. Plant Interact. 2017, 12, 421–428. [Google Scholar] [CrossRef]
- Orrego, F.; Ortiz-Calderón, C.; Lutts, S.t.; Ginocchio, R. Growth and physiological effects of single and combined Cu, NaCl, and water stresses on Atriplex atacamensis and A. halimus. Environ. Exp. Bot. 2020, 169, 103919. [Google Scholar] [CrossRef]
- Bi, Y.L.; Xue, Z.K. Dark septate endophyte inoculation enhances antioxidant activity in Astragalus membranaceus var mongholicus under heat stress. Physiol. Plant. 2023, 175, e14054. [Google Scholar] [PubMed]
- Zhang, Y.N.; Luan, Q.F.; Jiang, J.M.; Li, Y.J. Prediction and utilization of malondialdehyde in exotic pine under drought stress using near-infrared spectroscopy. Front. Plant Sci. 2021, 12, 735275. [Google Scholar] [CrossRef] [PubMed]
- Espanany, A.; Fallah, S.; Tadayyon, A. Seed priming improves seed germination and reduces oxidative stress in black cumin (Nigella sativa) in presence of cadmium. Ind. Crops Prod. 2016, 79, 195–204. [Google Scholar] [CrossRef]
- Fu, R.; Zhang, H.Y.; Liang, X.Y.; Li, M.; Li, J.L.; Song, Y.J.; Li, R.X.; Wang, X.Y. Physiological response of Mesembryanthemum cordifolium L. F. to salt and drought stresses. Shandong Agr. Sci. 2019, 53, 17–21. [Google Scholar]
- Chen, C.S.; Xie, Z.X.; Liu, X.J. Effects of drought and salt interactions on the growth of winter wheat seedlings and their physiological characteristics of stress tolerance. Chin. J. Appl. Ecol. 2009, 20, 811–816. [Google Scholar]
- Zhao, Q.Q.; Xu, H. Explore the changes of thiol compounds and antioxidant enzymes in Oudemansiella radicata mycelium under cadmium and lead stresses. J. Sichuan Univ. (Nat. Sci. Ed.) 2014, 51, 1051–1055. [Google Scholar]
- Dastogeer, K.M.G. Influence of fungal endophytes on plant physiology is more pronounced under stress than well-watered conditions: A meta-analysis. Planta 2018, 248, 1403–1416. [Google Scholar] [CrossRef]
- Xie, Y.J.; Wang, B.; Liang, X.H.; Han, Z.D. Effects of drought stress on reactive oxygen metabolism and protective enzyme activities in Glycyrrhiza seedlings. J. Agr. Sci. 2008, 29, 19–22. [Google Scholar]
- Zuo, Y.L.; Hu, Q.N.; Liu, J.Q.; He, X.L. Relationship of root dark septate endophytes and soil factors to plant species and seasonal variation in extremely arid desert in Northwest China. Appl. Soil Ecol. 2022, 175, 104454. [Google Scholar] [CrossRef]
- Tyagi, J.; Varma, A.; Pudake, R.N. Evaluation of comparative effects of arbuscular mycorrhiza (Rhizophagus intraradices) and endophyte (Piriformospora indica) association with finger millet (Eleusine coracana) under drought stress. Eur. J. Soil Biol. 2017, 81, 1–10. [Google Scholar] [CrossRef]
- Muhammad, I.; Yang, L.; Ahmad, S.; Mosaad, I.S.M.; Al-Ghamdi, A.A.; Abbasi, A.M.; Zhou, X.B. Melatonin application alleviates stress-induced photosynthetic inhibition and oxidative damage by regulating antioxidant defense system of maize: A meta-analysis. Antioxidants 2022, 11, 512. [Google Scholar] [CrossRef] [PubMed]
- Muhammad, I.; Yang, L.; Ahmad, S.; Farooq, S.; Khan, A.; Muhammad, N.; Ullah, S.; Adnan, M.; Ali, S.; Liang, Q.P.; et al. Melatonin-priming enhances maize seedling drought tolerance by regulating the antioxidant defense system. Plant Physiol. 2023, 191, 2301–2315. [Google Scholar] [CrossRef] [PubMed]
- Mayerhofer, M.S.; Kernaghan, G.; Harper, K.A. The effects of fungal root endophytes on plant growth: A meta-analysis. Mycorrhiza 2013, 23, 119–128. [Google Scholar] [CrossRef] [PubMed]
- Gaber, D.A.; Berthelot, C.; Blaudez, D.; Kovács, G.M.; Franken, P. Impact of dark septate endophytes on salt stress alleviation of tomato plants. Front. Microbiol. 2023, 14, 1124879. [Google Scholar] [CrossRef] [PubMed]
- Yuan, H.P.; Si, H.; Ye, Y.S.; Ji, Q.Y.; Wang, H.Y.; Zhang, Y.H. Arbuscular mycorrhizal fungi-mediated modulation of physiological, biochemical, and secondary metabolite responses in hemp (Cannabis sativa L.) under salt and drought stress. J. Fungi 2024, 10, 283. [Google Scholar] [CrossRef]
- He, C.; Han, T.T.; Tan, L.; Li, X.E. Effects of dark septate endophytes on the performance and soil microbia of Lycium ruthenicum under drought stress. Front. Plant Sci. 2022, 13, 898378. [Google Scholar] [CrossRef]

| Strain | Host Plant | Geographic Location | Acc. nr |
|---|---|---|---|
| Microsphaeropsis cytisi | Glycyrrhiza uralensis | Chifeng in Inner Mongolia | ON413886 |
| Autonomous Region | |||
| Stagonosporopsis lupini | Glycyrrhiza uralensis | Chifeng in Inner Mongolia | OP363602 |
| Autonomous Region | |||
| Neocamarosporium phragmitis | Glycyrrhiza uralensis | Jingtai, Gansu Province | ON413888 |
| Alternaria alstroemeriae | Isatis indigotica | Anguo, Hebei Province | MZ505449 |
| Macrophomina pseudophaseolina | Astragalus membranaceus | Anguo, Hebei Province | MZ506881 |
| Paraphoma radicina | Astragalus membranaceus | Anguo, Hebei Province | MT723853 |
| Papulaspora equi | Lycium ruthenicum | Minqin, Gansu Province | MW548086 |
| Alternaria tellustris | Lycium ruthenicum | Anxi, Gansu Province | OM936046 |
| Paraphoma chlamydocopiosa | Dendranthema morifolium | Anguo, Hebei Province | MT723851 |
| Macrophomina phaseolina | Salvia miltiorrhiza | Yaozhou, Shaanxi Province | OR434038 |
| Groups | Treatment Group | Methods |
|---|---|---|
| Control group | CK | 70% field water capacity |
| Cd stress group | Cd1 | 5 mg Cd/kg soil |
| Cd2 | 10 mg Cd/kg soil | |
| Cd3 | 15 mg Cd/kg soil | |
| Drought stress group | D | 40% field water capacity |
| Drought-Cd interaction stress group | DCd1 | 40% field water capacity and 5 mg Cd/kg soil |
| DCd2 | 40% field water capacity and 10 mg Cd/kg soil | |
| DCd3 | 40% field water capacity and 15 mg Cd/kg soil | |
| Inoculation group | Np | Inoculation with N. phragmitis |
| At | Inoculation with A. tellustris | |
| Non-inoculation group | C | No DSE inoculation |
| Strain | TI to PEG (%) | IC50 to PEG | TI to Cd2+ (mg Cd/L) | IC50 to Cd2+ | ||||
|---|---|---|---|---|---|---|---|---|
| 9 | 18 | 27 | (%) | 25 | 50 | 100 | (mg Cd/L) | |
| Microsphaeropsis cytisi | 0.95 | 0.72 | 0.58 | 30.84 (27.16–38.12) | 0.22 | 0.00 | 0.00 | ~22.53 |
| Alternaria alstroemeriae | 0.99 | 1.06 | 0.85 | ~28.51 b | 0.74 | 0.40 | 0.27 | 44.71 (39.98–49.92) |
| Stagonosporopsis lupini | 0.94 | 0.98 | 0.61 | 28.36 (~ 30.65) | 0.52 | 0.21 | 0.00 | 26.23 (24.19–28.14) |
| Neocamarosporium phragmitis | 0.87 | 1.02 | 0.57 | ~27.24 a | 0.54 | 0.39 | 0.33 | 29.58 (20.95–36.66) |
| Paraphoma chlamydocopiosa | 1.00 | 1.00 | 1.00 | - | 0.48 | 0.27 | 0.13 | 23.51 (22.30–24.66) |
| Macrophomina phaseolina | 1.00 | 1.00 | 1.00 | - | 0.43 | 0.20 | 0.14 | 19.25 (15.98–21.97) |
| Papulaspora equi | 0.97 | 0.49 | 0.00 | 17.97 | 0.43 | 0.22 | 0.00 | 22.07 (17.19–25.80) |
| Alternaria tellustris | 0.93 | 0.80 | 0.60 | 32.84 (30.34–36.63) | 1.01 | 0.87 | 0.56 | 109.30 (99.61–125.00) |
| Macrophomina pseudophaseolina | 1.00 | 1.00 | 1.00 | - | 0.43 | 0.20 | 0.00 | 22.08 (19.36–24.35) |
| Paraphoma radicina | 1.00 | 1.00 | 1.00 | - | 0.47 | 0.28 | 0.11 | 23.28 (21.77–24.69) |
Disclaimer/Publisher’s Note: The statements, opinions and data contained in all publications are solely those of the individual author(s) and contributor(s) and not of MDPI and/or the editor(s). MDPI and/or the editor(s) disclaim responsibility for any injury to people or property resulting from any ideas, methods, instructions or products referred to in the content. |
© 2024 by the authors. Licensee MDPI, Basel, Switzerland. This article is an open access article distributed under the terms and conditions of the Creative Commons Attribution (CC BY) license (https://creativecommons.org/licenses/by/4.0/).
Share and Cite
Wang, D.; Xie, Y.; Zhang, W.; Yao, L.; He, C.; He, X. Study on the Biological Characteristics of Dark Septate Endophytes under Drought and Cadmium Stress and Their Effects on Regulating the Stress Resistance of Astragalus membranaceus. J. Fungi 2024, 10, 491. https://doi.org/10.3390/jof10070491
Wang D, Xie Y, Zhang W, Yao L, He C, He X. Study on the Biological Characteristics of Dark Septate Endophytes under Drought and Cadmium Stress and Their Effects on Regulating the Stress Resistance of Astragalus membranaceus. Journal of Fungi. 2024; 10(7):491. https://doi.org/10.3390/jof10070491
Chicago/Turabian StyleWang, Duo, Yali Xie, Wanyi Zhang, Li Yao, Chao He, and Xueli He. 2024. "Study on the Biological Characteristics of Dark Septate Endophytes under Drought and Cadmium Stress and Their Effects on Regulating the Stress Resistance of Astragalus membranaceus" Journal of Fungi 10, no. 7: 491. https://doi.org/10.3390/jof10070491
APA StyleWang, D., Xie, Y., Zhang, W., Yao, L., He, C., & He, X. (2024). Study on the Biological Characteristics of Dark Septate Endophytes under Drought and Cadmium Stress and Their Effects on Regulating the Stress Resistance of Astragalus membranaceus. Journal of Fungi, 10(7), 491. https://doi.org/10.3390/jof10070491

